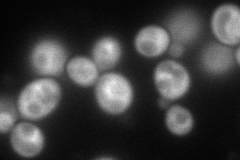
YLR196W
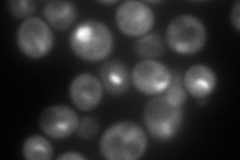
YLR196W
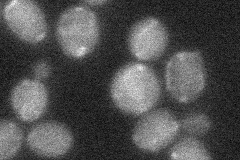
YLR196W
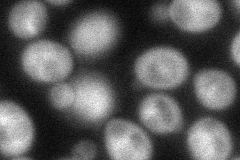
YLR196W

View description
Protein with WD-40 repeats involved in rRNA processing; associates with trans-acting ribosome biogenesis factors; similar to beta-transducin superfamily
Localization:
Intensity:
Fold change:
Significance:
-
C’ GFP library in SD

nucleus113.25 -
N' NOP1pr-GFP in SD
cytosol155.879 -
N' TEF2pr-mCherry in SD
nucleolus199.6 -
N' NATIVEpr-GFP in SD
punctate24.9257 -
N' TEF2pr-VC and Cyto-VN in SD
cytosol60.1971 -
C’ GFP library in SD+DTT

nucleus77.750.68No -
C’ GFP library in SD+H2O2

nucleus139.321.23No -
C’ GFP library in Starvation Media

punctateN/AN/AYes -
C’ GFP library on the background of Pup2-DaMP

nucleus -
C’ GFP library on the background of CCT mutant

nucleus126.0151.11258No
